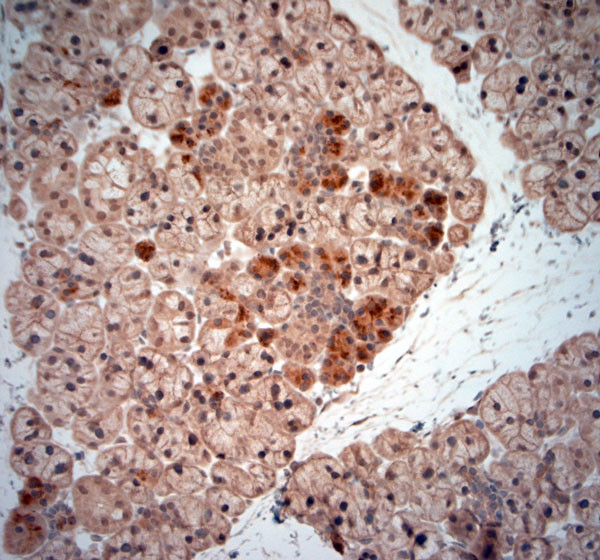
NGF Antibody in Immunohistochemistry (Paraffin) (IHC (P))

Search
Osenses
NGF Polyclonal Antibody
{{$productOrderCtrl.translations['antibody.pdp.commerceCard.promotion.promotions']}}
{{$productOrderCtrl.translations['antibody.pdp.commerceCard.promotion.viewpromo']}}
{{$productOrderCtrl.translations['antibody.pdp.commerceCard.promotion.promocode']}}: {{promo.promoCode}} {{promo.promoTitle}} {{promo.promoDescription}}. {{$productOrderCtrl.translations['antibody.pdp.commerceCard.promotion.learnmore']}}
图: 1 / 5
NGF Antibody (OSN00109W-100UL) in IHC (P)





产品信息
OSN00109W-100UL
种属反应
宿主/亚型
分类
类型
抗原
偶联物
形式
浓度
保存液
内含物
保存条件
运输条件
产品详细信息
Reconstitute in 100 µL of sterile water. Centrifuge to remove any insoluble material.
The peptide is homologous in rat and mouse.
Specificity of this antibody: NGF, appears to be only mature and not proNGF in the salivary gland at least.
靶标信息
Nerve growth factor (NGF) influences the survival and differentiation of a variety of neuronal and nonneuronal cells. The actions of this polypeptide result from binding to specific cell surface receptors which are present as both high and low affinity sites. Although both types of receptor bind NGF only the high affinity form is capable of signal transduction. Cross-linking studies with 125I-NGF have shown that the high affinity receptor of rat PC12 cells forms an Mr 158,000 complex with NGF while the low affinity receptor forms an Mr 100,000 complex. Full length cDNA clones for both the human and rat NGF receptor genes have been produced and sequenced, revealing greater than 90% homology between the two species. NGF exhibits nerve growth stimulating activity and is involved in the regulation of growth and the differentiation of sympathetic and certain sensory neurons. Further, NGF stimulates division and differentiation of sympathetic and embryonic sensory neurons. Mutations in the NGF gene have been associated with hereditary sensory and autonomic neuropathy, type 5 (HSAN5), and dysregulation of NGF gene expression is associated with allergic rhinitis.
仅用于科研。不用于诊断过程。未经明确授权不得转售。
生物信息学
蛋白别名: B nerve growth factor; b-NGF; beta ngf; Beta-nerve growth factor; Beta-NGF; BetaNGF; bNGF; MGC161426; MGC161428; Nerve growth factor; nerve growth factor (beta polypeptide); nerve growth factor, beta; nerve growth factor, beta subunit; NGF b; NGF β; NGFB; NGFbeta; NGFβ; pro-nerve growth factor long; unnamed protein product; β nerve growth factor; β NGF; βNGF
基因别名: Beta-NGF; HSAN5; NGF; NGFB
UniProt ID: (Human) P01138, (Mouse) P01139, (Rat) P25427
Entrez Gene ID: (Human) 4803, (Mouse) 18049, (Rat) 310738